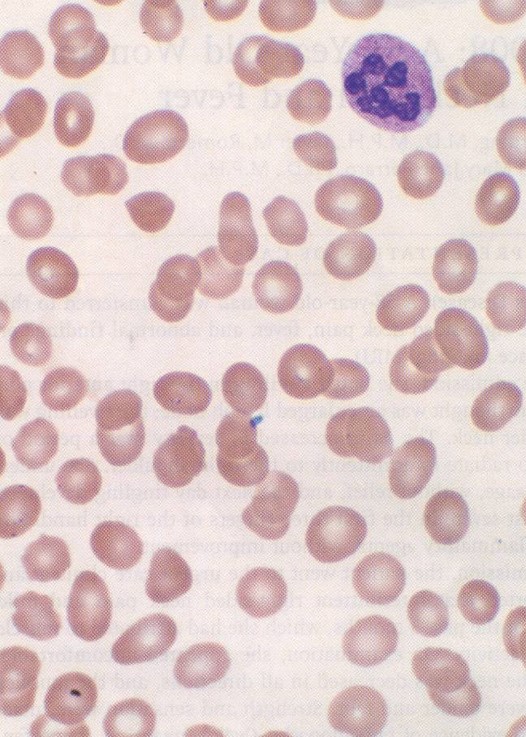

Last Week's Medical Mystery
You are asked to review the peripheral blood smear and bone marrow aspirate (see below) taken from a 70-year-old woman who presents with pancytopenia. What is your diagnosis, what furher clinical and laboratory tests would you do/order to confirn your suspicions, and what treatment, if any, do you recommend?

DIAGNOSIS: Vitamin B12 deficiency, in this case due to a lack of intrinsic factor absorption (pernicious anemia).
Note the oval macrocytes and the 6-lobed neutrophil in the peripheral smear and the megaloblastic features of the bone marrow (large erythroblasts with primititve appearing nuclei and giant abnormally shaped metamyelocytes). Pancytopenia can occur in severe cases of cobalamin or folate deficiency.
In addition to symptoms and signs of anemia (e.g., fatigue, pallor, Hunter's glossitis) B12 deficiency may be accompanied by neurologic deficits secondary to degenerative changes in the posterior column and in periventricular white matter. Hence patients with B-12 deficiency may demonstrate a positive Romberg sign (when standing with feet touching and arms extended, the patient is stable with eyes open and unstable with eyes closed) and/or dementia - both of which are reversable with B12 treatment.
In addition to pernicious anemia, B12 deficiency may occur in patients with autoimmune polyendocrinopathy type 1, inadequate dietary intake (i.e., in vegans), malabsorption (atrophic gastritis, Zollinger-Ellison syndrome, gastric bypass or bariatric surgery), in gluten-induced enteropathy, severe pancreatitis, HIV infection, abdominal radiotherapy, graft-versus-host disease, and in patients treated with colchicine, para-aminosalicylate, neomycin, slow-release potassium chloride, anticonvulsive drugs, metformin, proton-pump inhibitors, and cytotoxic drugs.
The diagnosis of pernicious anemia is established by measuring blood levels of type I autoantibody (˜55% of patients; blocking antibody that prevents cobalamin from binding to intrinsic factor) and type II autoantibody (˜35% of patients; binding antibody that prevents attachment of intrinsic factor to ileal mucosa).
Initial treatment of pernicious anemia consists of six 1000 ug IM injections of hydroxocobalimin given at 3- to 7-day intervals. For maintainence,1,000 ug IM injections of hydroxocobalimin are given once every 3 months. Large daily oral doses (1000-2000 ug) of cyanocobalamin have also been used as maintainence therapy.
 Stout Drive Road Closure
Stout Drive Road Closure